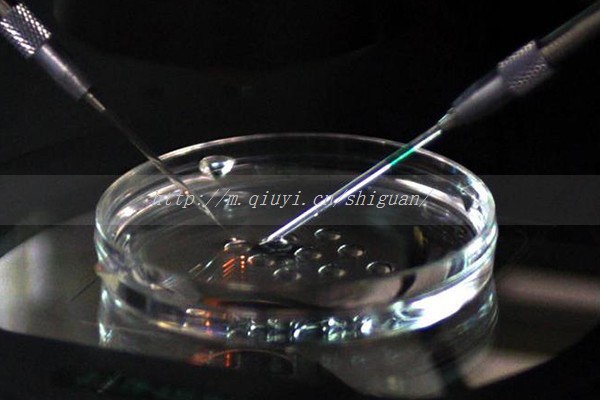

2023年在沈阳私立医院做供卵三代试管婴儿费用大概多少?
2023年在沈阳私立医院做供卵三代试管婴儿费用大概多少?这是一个值得思考的问题,由于私立医院的收费标准不同,费用也会有所差异。供卵三代试管婴儿所需费用供卵三代试管婴儿费用主要包括医院检查费、处方药费、试管婴儿技术费、卵子捐赠费、冷冻保存费、

为了在嘉峪关助孕试管婴儿中获得好的精子男性该怎么办?
经过试管婴儿进周前的一系列准备、频繁的促排监测,终于熬到取卵日,但是你知道吗,在取卵当日男性也需要进行取精,取精虽然看似简单,其实需要注意的事情还是很多的。那么,试管婴儿中为了取得好的精子男性应该怎样做呢?这些事项男性需注意1、禁欲GEQ育
抚州试管婴儿:抚州三代试管哪家医院成功率高
随着现代医学技术的不断发展,三代试管技术已成为治疗不孕不育的重要手段之一。抚州地区也有多家医院提供此项服务,那么抚州三代试管哪家医院成功率高呢?本文将为您介绍相关知识。根据统计数据和患者反馈,抚州市第一人民医院、江西省中医院和抚州市妇幼保健

徐州三代试管婴儿的费用大约是多少
徐州三代试管婴儿的费用大约是多少?三代试管婴儿是一种高科技辅助生殖技术,可以帮助许多不能自然受孕的夫妻实现生育梦想。那么徐州三代试管婴儿的费用大约是多少呢?根据目前市场行情来看,徐州地区三代试管婴儿的费用大约在50-80万元之间。什么是三代

三代试管包女孩价格多少?
第三代试管技术介绍,接下来最新发布三代试管包女孩价格多少?相关内容,供大家参考!第三代试管婴儿又称胚胎植入前细胞生物学无损检测技术,主要帮助识别胚胎是否有遗传病或性染色体数目和结构异常。在整个过程中,我们必须利用显微镜的实际操作技术,从体外

山东大学附属生殖医院三代试管生男孩多少钱
经过多年的技术研究,山东大学附属生殖医院的试管婴儿技术已发展到第三代,因此可作为第三代试管婴儿。但需要注意的是,我国不允许通过试管婴儿进行性别选择。第三代体外受精的初衷是筛选基因缺陷和遗传疾病的胚胎,帮助患者生下没有遗传疾病的健康婴儿,而不

去做试管怎么向私人单位请假_爸爸妈妈开心了
去做试管怎么向私人单位请假_爸爸妈妈开心了?试管婴儿(in-vitrofertilization,IVF)是一种技术,可以帮助不孕不育的夫妇实现愿望,让他们拥有自己的孩子。但是参加IVF治疗的夫妇需要面对诸多困难,其中最重要的是请假的问题。

西安三代试管哪些医院_西安三代试管能选性别吗
近日,西安市卫健委发布了《关于规范生殖医学技术临床应用的通知》,其中明确规定三代试管婴儿不能选择性别。那么到底什么是三代试管?为什么不能选性别?下面就来详细解读一下。什么是三代试管婴儿?三代试管婴儿指的是第三代体外受精-胚胎植入技术,即在人

5个月的新生儿用国产隔尿垫什么牌子好?
5个月的新生儿用国产隔尿垫什么牌子好?个人感觉国产隔尿垫良良品牌还是很不错的,深受广大妈妈们的喜爱,隔尿垫不是纸尿裤,也不是尿布,它的主要作用是隔离尿液,以保证下面的褥子或床垫不被尿液浸湿,隔尿垫湿了最好立即更换,以保证宝宝的屁股干爽。下面
患友评价

To:试管婴儿可以选择男女性别吗?看看你是否满
从试管婴儿这一辅助生殖技术问世以来,一直都存在着质疑的声音,但在试管婴儿技术帮助不孕不育夫妇达成生

To:卵巢健康对试管婴儿成功率有影响吗?学好5招
如今,随着试管婴儿技术的发展,大多数不孕不育夫妇都会选择做试管婴儿来帮助自己怀孕,而且随着试管婴儿

To:试管婴儿囊胚培养优势是什么?什么情况下适
通常情况下,在做试管婴儿中会在卵子取出后与精子受精结合培养到3天左右形成胚胎,而若再在这一基础上继续

To:试管婴儿出现空囊的几率大吗?到底哪里出了
空囊是指女性停经50天左右,动态观察宫腔内只有一个空孕囊,囊内没有胎胚,此时胚胎也不能够继续发育。空

To:试管婴儿后遗症有哪些?别等出现了才知道!
现今,试管婴儿这项技术受到了不孕不育夫妇极大的关注和重视,很多不孕不育夫妇都原因通过做试管婴儿来达

To:做试管婴儿女性痛苦吗?全过程揭秘,看完才
生育难是现代社会普遍存在的一个问题。而随着辅助生殖技术的发展,试管婴儿逐渐进行了人们的视野之中,一

To:泰国试管婴儿医院成功率高吗?这3家医院不容
随着试管婴儿技术的成熟发展,多数不孕不育家庭都得到了这一技术的帮助,达成了生育这一目的。不过对于还

13797066821
复制微信号进群



